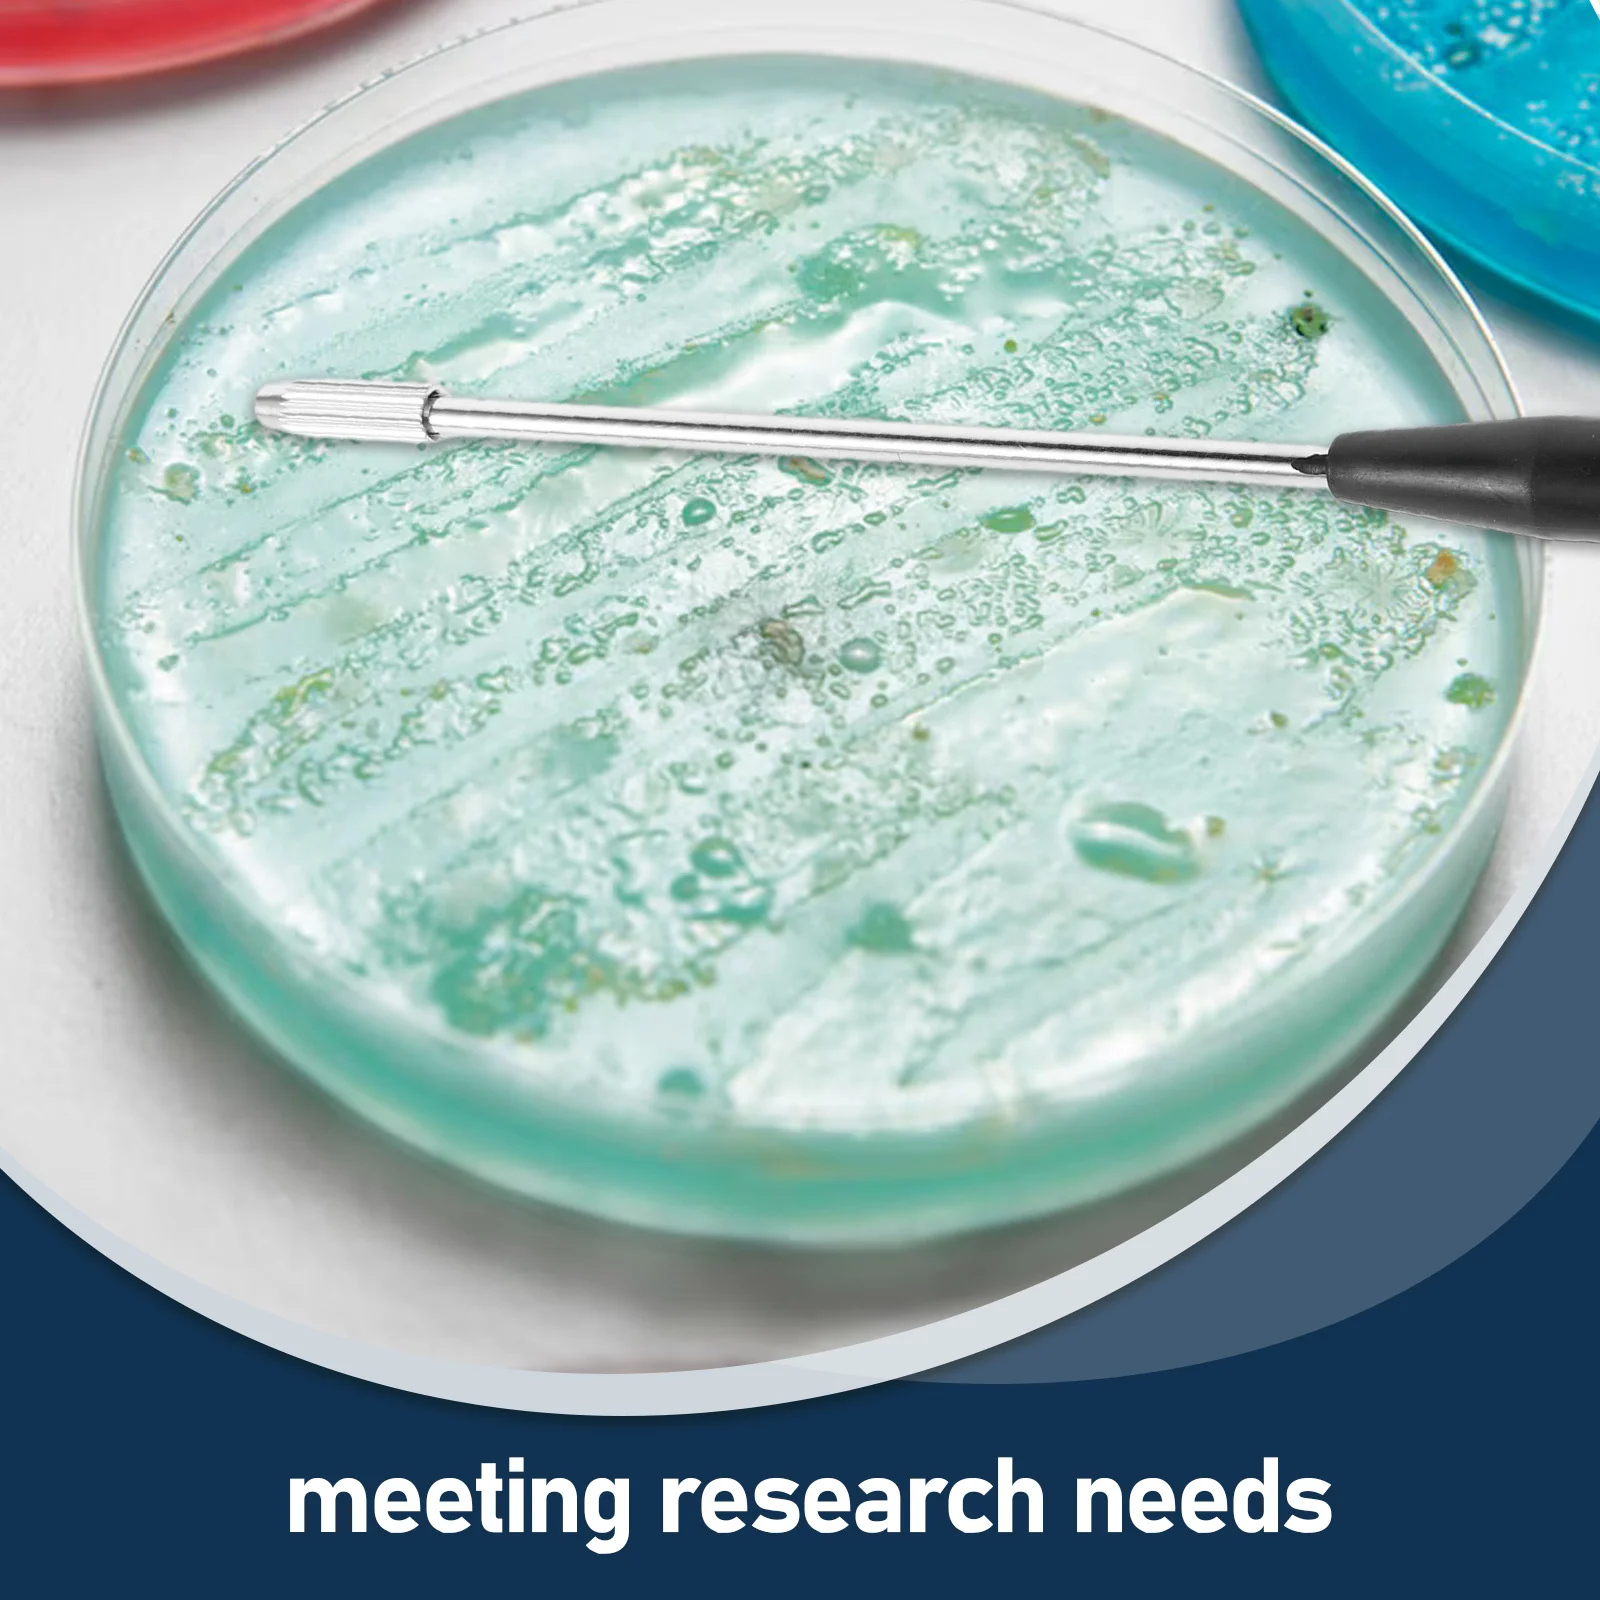
thumb
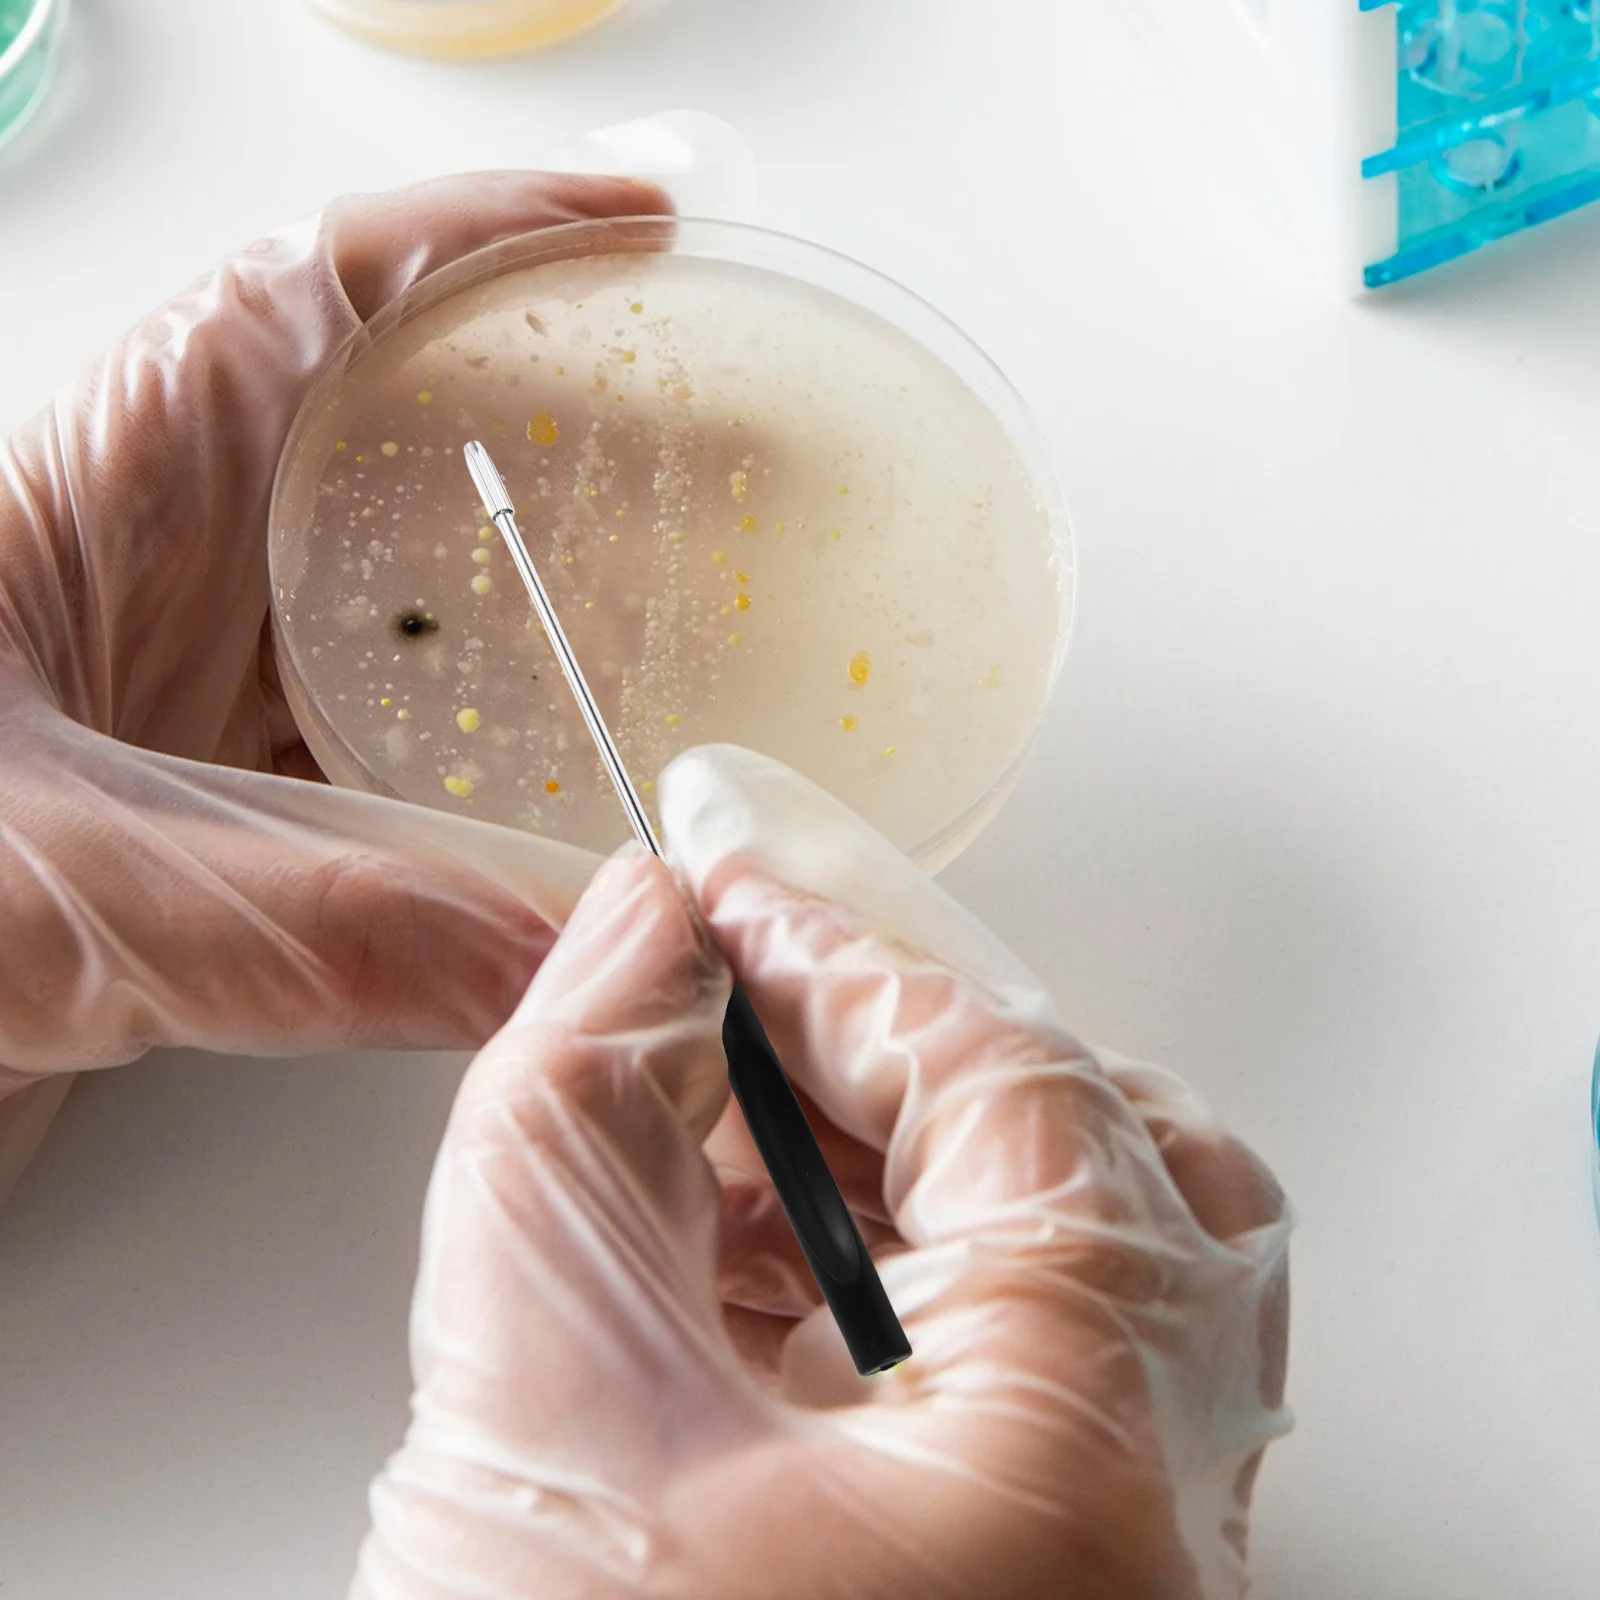
thumb

4 Pcs Sterile Inoculation Tools Inoculating Loops Rod Device Copper Sticks Probe
Price history chart & currency exchange rate
Customers also viewed

$5.89
Self-adhesive Acrylic Nano Adhesive Tape Clear Removable Double Sided Strong Traceless Tape Transparent Waterproof Reusable Tape
aliexpress.com
$20.16
LSUC car mounted capacitor emergency power supply 2.8V600F, 6 units per set, 16V100F power system, grid renovation buffer
aliexpress.com
$8.18
Travel Jewelry Roll Foldable Cases for Jewelry Packing Necklace Bracelets Earrings Watch Storage Bag
aliexpress.com
$12.78
Radiator Panel Cover Fan Cover Radiator Protection Grille Carbon Fiber Pattern for Yamaha NMAX 155 NMAX155 V2 2020 2021
aliexpress.com
$48.95
20cm sexy ultra-thin high-heel sandals, party pole dancing slippers.Sexy buckle decorative waterproof table slippers
aliexpress.com
$231.57
Genuine Auto Parts Transmission Oil Pump A6LF3 A6LF2 for Hyundai Kia 461003B000
aliexpress.com
$10.94
Summer New Pet Princess Dress Breathable Cotton Material Skirt with Traction Buckle Small Medium Dog Cat Clothing Pet Apparel
aliexpress.com
$3.18
Car Air Vent Perfume Air Freshener Lasting Fragrance For BMW X3 X5 M5 M3 E46 E90 E60 F10 E39 F30 E36 G30 E87 E70 E91 E30 G20
aliexpress.com
$150.00
OPPO Reno 5 Pro Plus 5G LCD Display Touch Screen Digitizer Replacement PDRM00, PDRT00 Reno 5 Pro Plus 5G LCD Screen Display
aliexpress.com
$10.95
Hot Scooter Leg Cover Electric Car Windproof Quilt Scooter Windproof Rain Proof Plush Thick Warm Motorcycle Leg Apron Cover
aliexpress.com
$26.25
Tapiz colgante medieval, arte de pared, tapiz grande, mural, decoración, fotografía, telón de fondo, manta, cortina, hogar, dormitorio, sala de estar, decoración
miniinthebox.com
$54.66
Combinaison Femme Maille Strass Bloc de couleur Col V Casual Soirée Travail Standard manche longue Blanche S Automne
miniinthebox.com
$41.53
Herren Stiefel Komfort Schuhe Casual Klassisch Täglich Büro Karriere PU Stiefeletten / Stiefeletten Silber Schwarz Herbst Frühling
miniinthebox.com
$19.80
DIY Sewing-on PU Leather Steering Wheel Cover Exact Fit For Skoda Octavia 2017 Fabia 2016-2017 Rapid Superb
aliexpress.com
$56.81
CHICIEVE Popular Bedding Set Beautiful Delicate Cheap And Good Quality Bedding Set Fashion King Size Quilt Cover Bed Sheet Retro
aliexpress.com
$34.88
Bearbricklys 28cm 400% Bear&bricklys Toy Blocks Bear Toy Action Toy Figures Garage Kits Dolls Kids Toys
aliexpress.com
$2.45
1Pcs Sushi Maker Kit Rice Roll Mold Kitchen DIY Onigiri Rice Roller Kitchen Gadgets Cooking Accessories Bamboo Sushi Maker Tools
aliexpress.com
$17.65
Women Flats Faux Suede Slip on Flat Shoes Woman Loafers Metal Boat Shoes Soft Female Shoes Black zapatos mujer
aliexpress.com